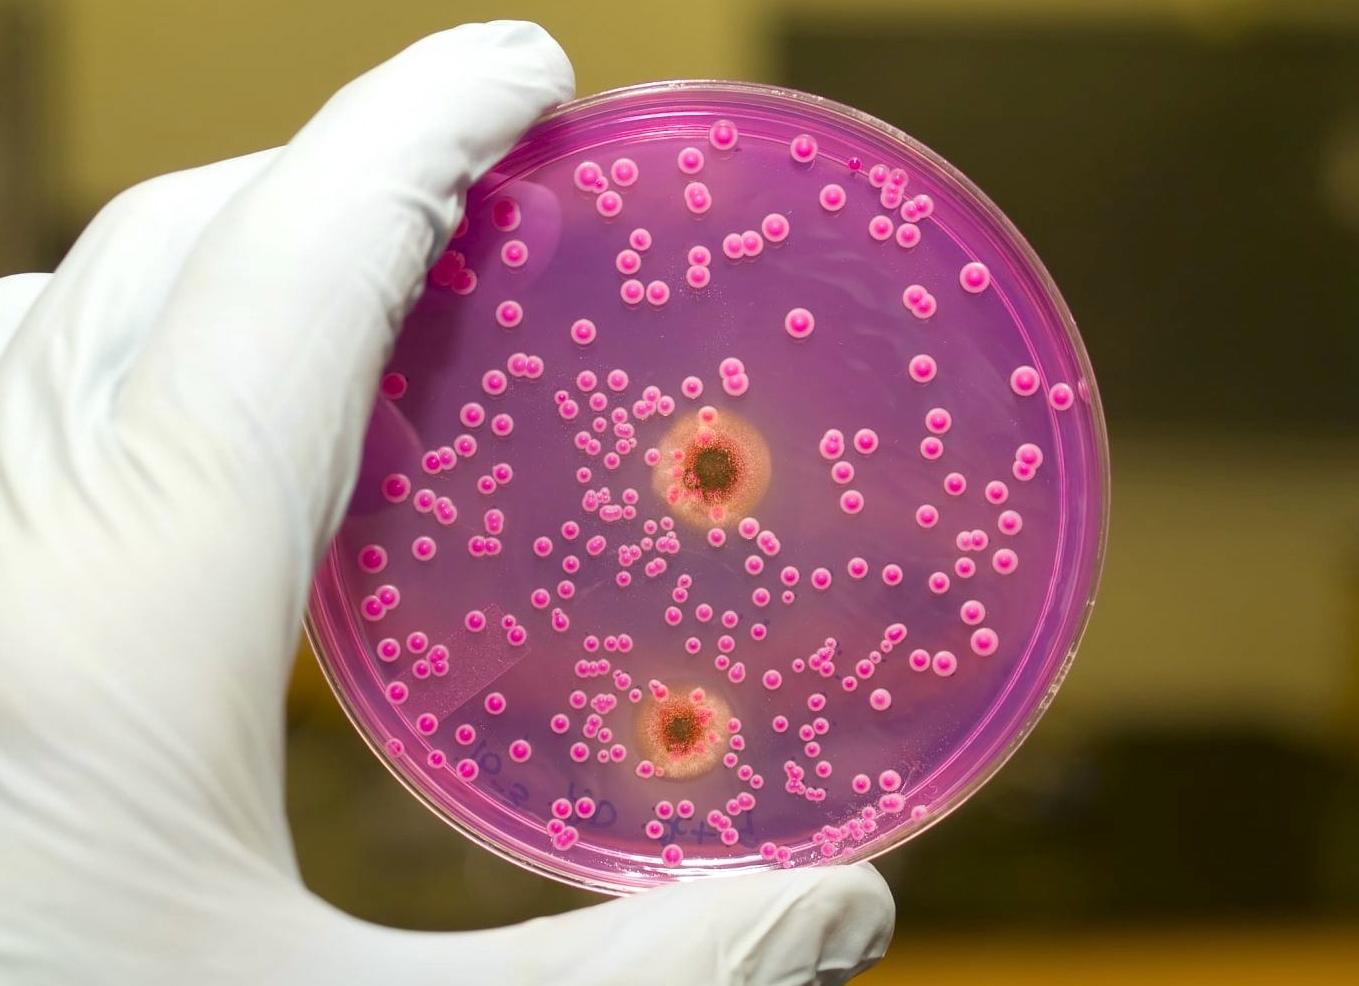
Чем опасен трихомониаз Чем опасен трихомониаз

Чем опасна густая кровь
[Чем опасна густая кровь]
ЧЕМ ОПАСНА ГУСТАЯ КРОВЬ?в закладки 16
ЧЕМ ОПАСНА ГУСТАЯ КРОВЬ И ЧТО НАДО ДЕЛАТЬ?
Некоторые знают, что густую кровь надо разжижать. Замедленный кровоток приводит к кислородному голоданию внутренних органов. И к возможному образованию тромбов.
Итак, что нужно делать, чтобы кровь свободно циркулировала. Несколько простых советов.